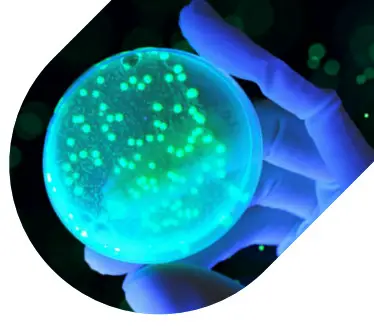
Yoda Bactiscan - Figure 9

Bactiscan
User Manual
INTRODUCTION
Thank you for purchasing the EIT Bactiscan™ rechargeable bacteria and biofilm detection lamp, our latest innovation offering an all-in-one solution that combines a high-performance lamp in a single lightweight, IP67-rated compact unit.
Rechargeable Bacteria and Biofilm Detection Lamp
PARTS:

- Lens
- On/Off Button
- Adjustable stand
- Charging base
- DC charger
Important Warnings
Please read these instructions carefully to ensure the safe and effective use of this product.
- Read the manual before use
- Always use the charger supplied, and never use a damaged charger or alternative charger
- Disconnect from any power sources and switch off, before performing any routine cleaning or maintenance
- Leave servicing to a qualified person. In case of any problems or questions please contact your local Authorised Bactiscan™ Reseller or contact EIT direct at
[email protected] - Do not shine the light directly into people’s eyes, as it may damage their eyesight
- Keep out of reach of children
RECHARGEABLE BACTERIA AND BIOFILM DETECTION LAMP
With Bactiscan’s™ unique wave alternating UV system, Bactiscan™ enables food processors to immediately isolate Biofilms, mold, and bacteria such as salmonella and E.coli and many other contaminants are easily located and identified with Bactiscan™ which makes the remediation job much faster and therefore more cost effective.
These contaminants are often undetectable using other methods such as white light and UV lamps. With Bactiscan™ you can light up the entire surface and get an immediate result, so within seconds, you can pick things up that would take hours with any other method.
HANDHELD BACTERIA AND BIOFILM DETECTION SYSTEM
Environmentally friendly wave-altering UV to quickly identify areas harboring bacterial contaminants such as E.coli, listeria, and salmonella which are often missed under standard white light or UV lamp.
Normal View
The item looks clean and normal under white light or standard UV
Bactiscan™ View
Clearly reveals contamination
Specification
| Runtime | |
| Product | Bactiscan™ |
| Power On | 1h 30mins |
| Charge Time | 6hrs 30mins |
| IP Rating | IP67 |
| Battery | 7.4V 6.6Ah Li-ion |
| Impact Resistance | 1.5 Metres |
| Charge Base | Ye s |
| Vehicle Charger | Ye s |
| Dimensions | 250 x 125 x 120 (mm) |
| Weight | 1.0KG |
OPERATING THE BACTISCAN™
Bactiscan™ illuminates a surface via 4 separate UV lights. These lights are UV-A type and are safe for short use. It is always recommended that the user wear eye protection (not supplied) when operating Bactiscan™. To switch it ON, simply hold the grey button and the Bactiscan™ will turn on. To turn the lamp OFF, release the grey button.

CHARGING
- Slide the Bactiscan™ inside the charging base, push until it slots in the back and connects with the charging ports.

- Connect the charger lead to the input socket at the back of the charging base.

- Plug the charger into a suitable socket outlet. Turn the switch on. The indicator on the charger will illuminate red when charging and green when fully charged.

- To release the Bactiscan™ from the charging base, hold and pull the release levers towards you, and use your thumb to push the Bactiscan away from the charging slot as shown in the picture.

- Once the Bactiscan™ is released slide the lamp out of the charging base.
The Bactiscan™ unit is ready to be used.
Bactiscan™ uses smart battery technology. When the battery is fully charged battery will fall into sleep mode and will maintain a full charge via trickle charge. It is safe to leave Bactiscan™ plugged in whilst in its cradle. Please note: The battery will reach optimum performance after 5 complete discharge/charge cycles.
MOUNTING THE CHARGING BASE
Mounting the charging base The Bactiscan™ lamp is supplied with a charging base, providing a convenient way to charge it. The base can be used flat on a desk or fixed on a wall or a vehicle. The charging base has four mounting holes, measurements are shown in Figure 1. Make sure the M5 fixings screws used to mount the charging base, are strong enough to support the weight of the Bactiscan™. Take care not to over-tighten the fixings and mount on a flat/level surface, so the charging base isn’t distorted or damaged.
Figure 1
The holder may be mounted on either horizontal or vertical panels. Mount using four M5 fixing screws.

SAFE DISPOSAL OF WASTE ELECTRICAL PRODUCTS AND BATTERIES
If at any time, you need to dispose of this product or parts of this product: Please note that waste electrical products and batteries should not be disposed of with ordinary household waste. Recycle where facilities exist. Check with your local authority for recycling advice. Alternatively, Yoda Health & Environmental Solutions is happy to take receipt of this product at end-of-life and will recycle it on your behalf.

WARRANTY
The Bactiscan™ products have a 1-year standard warranty on all manufacturing defects and 1-year warranty on all rechargeable batteries from the date of purchase.
Yoda Health & Environmental Solutions warrants this product free from defects in material and workmanship for a period of 1 year from the date of purchase. This warranty does not cover damage caused by misuse or abuse, accident, the attachment of any unauthorized accessory, alteration to the product, or any other conditions whatsoever that are beyond the control of Yoda Health & Environmental Solutions.
CAUTION!
Modifications not expressly approved by EIT International may void the user’s authority to operate the equipment. The removal of any panels or components, or to open of the sealed Bactiscan™ casing will render the equipment damaged and will void any Warranty in place (see Page 7– Warranty).
A damaged Bactiscan™ unit through the malice of any third party will render the equipment written off and the user will be liable for all costs associated with the repair or replacement of the unit.
Yoda Health & Environmental Solutions LTD. is registered in the Republic of Ghana under number C0060905654 and the Federal Republic of Nigeria under number 1801857.
BEAVER HOUSE – HEAD OFFICE
AGOSTINHO NETO RD
AIRPORT RESIDENTIAL AREA
PO BOX OS 2778
ACCRA GHANA
[email protected]
General/Sales:
GH: +233 59691 4339
NG: +234 81031 74193
Support: GH: +233 24102 9940
NG: +234 81031 74193
FOR FURTHER INFORMATION, VISIT
YODAHES.COM






















